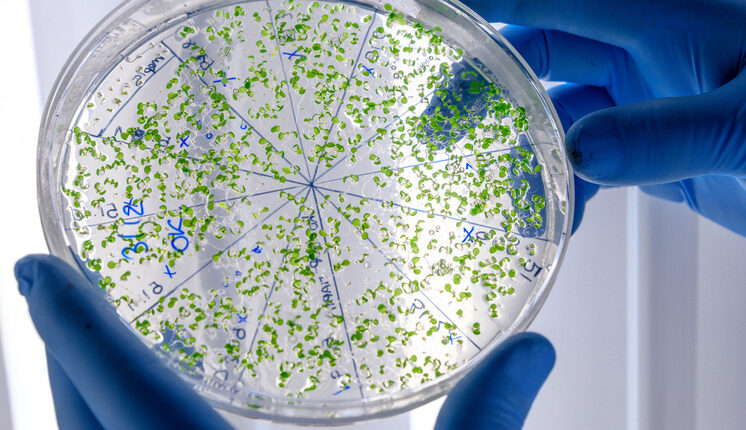

Опубликован список “приоритетных патогенов”: представляют наибольший риск для общественного здравоохранения
Минздрав Великобритании опубликовал новый перечень особо опасных вирусов и бактерий Поделиться
Официальные лица выпустили новый список «приоритетных патогенов», представляющих наибольший риск для общественного здравоохранения. Агентство по безопасности здравоохранения Великобритании заявляет, что его руководство призвано помочь ученым и исследователям сосредоточить свои усилия и повысить готовность к любой будущей пандемии.
тестовый баннер под заглавное изображение
Представители британского министерства здравоохранения опубликовали новый список вирусов и бактерий, которые, по их мнению, представляют наибольшую угрозу для общественного здоровья, рассказывает Sky News.
Агентство по безопасности здравоохранения Великобритании (UKHSA) сообщает, что его руководство "Приоритетные патогены" призвано помочь ученым и исследователям сосредоточить свои усилия и повысить готовность к любой будущей пандемии.
Список из 24 семейств патогенов является первым, в котором рассматриваются глобальные угрозы здоровью, а также угрозы, характерные для населения Великобритании, и есть надежда, что это ускорит разработку вакцин, отмечает Sky News.
Семейства вирусных патогенов, классифицируемых с высоким риском возникновения как эпидемий, так и пандемий, включают: коронавирусы, к которым относится COVID-19; ортомиксовирусы, к которым относится птичий грипп; парамиксовирусы, вызывающие вирус Нипах.
Доктор Изабель Оливер, главный научный сотрудник UKHSA, комментирует: "Мы живем во времена растущих вызовов и рисков, связанных с инфекционными заболеваниями. Но в то же время, благодаря научному прогрессу, у нас есть лучшие инструменты, чем когда-либо, для защиты здоровья от этих угроз".
"Тем не менее, – подчеркивает доктор Оливер, – есть области, где мы все еще нуждаемся в большей или более совершенной диагностике, вакцинах, лекарствах и терапии, и этот инструмент был разработан для того, чтобы помочь в информировании государственных спонсоров исследований, а также наших партнеров в промышленности и научных кругах, которые играют решающую роль в разработке этих инструментов, в которых мы так отчаянно нуждаемся".
Чтобы создать инструмент, эксперты оценили пандемический и эпидемиологический потенциал каждого семейства вирусов, проанализировав тяжесть заболевания, пути передачи и предыдущие пандемии среди известных патогенов этого семейства, отмечает Sky News.
Затем каждой группе был присвоен рейтинг высокого, среднего или низкого риска, основанный на мнении ученых из UKHSA.
Этот инструмент также содержит информацию о том, чувствителен ли риск к изменению климата, имеются ли вакцины и возможна ли передача инфекции от человека к человеку, а также об их устойчивости к лекарственным препаратам, таким как антибиотики.
Доктор Оливер подчеркивает: "Мы не составили рейтинг, потому что ситуация, как вы можете себе представить, постоянно меняется, и одна из задач, которую мы выполняем в UKHSA, – это наблюдение и мониторинг угроз".
Она добавила: "Это важный урок из пандемии COVID-19, который заключается в том, что нам действительно важно учитывать широту потенциальных угроз здоровью и продолжать отслеживать ситуацию и гибко реагировать на них. Таким образом, наш подход в значительной степени направлен на повышение нашей устойчивости ко всем семьям, о которых идет речь, и на сотрудничество с партнерами для повышения устойчивости ко всем этим семьям".

Комментарии закрыты.